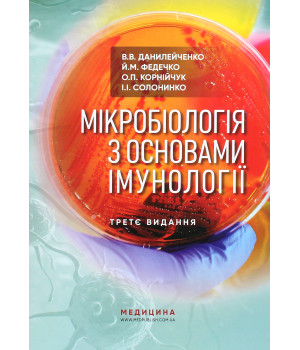
Книга Мікробіологія з основами імунології. Підручник

Видавництва
У навчальному посібнику висвітлено питання історії розвитку паліативної медицини, особливості наданн..
736.00 грн.
920.00 грн.
Видання містить 4 розділи («Ендокринологія», «Пульмонологія», «Гастроентерологія», та «Гематологія»)..
304.00 грн.
380.00 грн.
Видання містить 4 розділи («Ендокринологія», «Пульмонологія», «Гастроентерологія», та «Гематологія»)..
384.00 грн.
480.00 грн.
Навчальний посібник «Біохімічні показники в нормі і при патології» — важливий ресурс для медичних пр..
904.00 грн.
1 130.00 грн.
авчальний посібник «Невідкладні стани в клініці внутрішньої медицини» є важливим джерелом інформації..
880.00 грн.
1 100.00 грн.
У навчальному посібнику висвітлено сучасні погляди на зміст, класифікацію, відмінні особливості, фіз..
1 344.00 грн.
1 680.00 грн.
У посібнику представлено розділи з фізіологічного впливу масажу на організм людини та гігієнічних ос..
508.00 грн.
635.00 грн.
У навчально-методичному посібнику подано теоретичні відомості про будову тіла людини і фізіологічні ..
328.00 грн.
410.00 грн.
Теоретичний матеріал викладено згідно з навчальною програмою. Навчальний посібник допоможе студентам..
564.00 грн.
705.00 грн.
Цей сучасний, стислий, проте ґрунтовний посібник з імунології створено професійним колективом авторі..
1 120.00 грн.
1 400.00 грн.
У підручнику викладено матеріал з основ реабілітації, фізіотерапії, лікувальної фізкультури, масажу ..
832.00 грн.
1 040.00 грн.
У національному підручнику з позицій класичної медицини та сучасних наукових досягнень подано топічн..
1 432.00 грн.
1 790.00 грн.
У посібнику наведено комплексний огляд ведення онкологічних хворих із різною локалізацією пухли..
1 616.00 грн.
2 020.00 грн.
«Онкологія» у редакції Г.В. Бондара, А.I. Шевченка, I.Й. Галайчука та Ю.В. Думанського — це дру..
1 136.00 грн.
1 420.00 грн.
е четверте осучаснене популярне видання зі вступу до офтальмології. Перше видання було відзначено пр..
948.00 грн.
1 185.00 грн.
Підручник складено відповідно до навчальної програми з дисципліни «Мікробіологія з основами імунолог..
912.00 грн.
1 140.00 грн.
«Атлас анатомії людини з латинською термінологією» стане всебічним джерело знань, яке поєднує деталі..
2 880.00 грн.
3 600.00 грн.
Повністю перероблений і оновлений, посібник «Тривога і фобія. Робочий зошит» за авторством Едмунда Д..
788.00 грн.
985.00 грн.